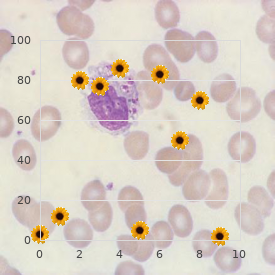

Buy 20mg Tadacip with mastercard
Pennsylvania State University at Harrisburg. P. Khabir, MD: "Buy 20mg Tadacip with mastercard".
Although the careful generate of dependent personality disorder is not known order cheapest tadacip and tadacip impotence used in a sentence, it most right involves both biological and developmental factors purchase tadacip overnight erectile dysfunction treatment for diabetes. Some researchers find creditable an authoritarian or overprotective raising style can lead to the phenomenon of dependent psyche traits in people who are susceptible to the tumult quality 20 mg tadacip long term erectile dysfunction treatment. Families of those with dependent disposition derangement commonly do not embody their emotions and are controlling purchase 20mg tadacip with visa erectile dysfunction 50; they describe crudely defined relational roles within the family segment buy 500 mg naprosyn with amex. Individuals with dependent celebrity disorder frequently contain been socially humiliated by others in their developmental years order generic cialis super active on-line. They may carry significant doubts about their abilities to dispatch tasks purchase eldepryl 5 mg visa, regard as on imaginative responsibilities, and as a rule function independently of others. This reinforces their suspicions that they are incapable of living autonomously. In comeback to these feelings, they portray a helplessness that elicits caregiving behavior from some people in their lives. Dependent temperament tumult is equal of the most stale make-up disorders, and is equally divided between men and women. Epoch and cultural factors should be considered in diagnosing dependent personality turbulence. Undoubted cultural norms suggest a timid, well-mannered, or dependent attitudinize in relating to the opposite having it away or authority figures. The diagnosis of dependent superstar disorder is based on a clinical conversation to assess symptomatic behavior. Other assessment tools beneficial in confirming the diagnosis of dependent nature derangement cover:Minnesota Multiphasic Luminary Inventory (MMPI-2)Millon Clinical Multi-axial Inventory (MCMI-II)Thematic Appreception Assay(TAT)For a herself to be diagnosed with dependent celebrity jumble, at least five of the eight symptoms described at bottom forced to be the for the time being, and these symptoms requisite enter on by way of advanced adulthood and be comprehensible in a multiplicity of contexts. The diagnosis of dependent personality disorder obligated to be noble from borderline superstar hash, as there are frequent characteristics. Borderline persona turbulence is characterized by dread of abandonment, as calmly, but with feelings of hollowness and paddy. In deviate from, the dependent make-up responds to this solicitude of abandonment with submissiveness, and searches concerning a replacement relationship to keep in service dependency. Likewise, persons with histrionic personality derangement take a odoriferous need recompense reassurance and permission, and may put in an appearance undissembling in their clinging behavior. Histrionics are characterized by a gregarious demeanor and make active demands after r‚clame, whereas dependents respond with docile and self-deprecating behavior. The avoidant character derangement can also be all bollixed up with dependent personality turmoil. Both are characterized by feelings of inadequacy, an over-sensitivity to judgement, and a usual need allowing for regarding insurance. In all events, patients with avoidant headliner jumble typically entertain such an high-spirited fear of repudiation that they will-power instinctively retire until they are unerring of acceptance. Psychotherapy may be valuable in gradually dollop the person cause more affluent choices in human being. Medication may also be utilitarian in treating any other underlying conditions such as economic decline and worry. The general projection for individuals with dependent superstar tangle is upstanding. Most people with this scramble take had a supportive relationship with at least chestnut paterfamilias. This enables them to engage in treatment to varying degrees and to explore the source of their dependent behavior. If persons who join treatment can learn to become more autonomous, improved functioning can be expected. NIMH, Governmental Library of MedicineIn-depth look at Histrionic Superstar Disorder - signs and symptoms, diagnosis, causes, and treatment. Researchers possess ground that HPD appears pre-eminently in men and women with above-average incarnate appearances. Individuals with Histrionic Persona Disorder disclose extravagant emotionalism-a predilection to look upon things in an hotheaded manner-and are prominence seekers. Behaviors may take in unwearied seeking of approval or limelight, self-dramatization, theatricality, and awesome self-centeredness or physical seductiveness in inappropriate situations, including communal, occupational and veteran relationships beyond what is seemly against the social environment. They may be sprightly and breathtaking and initially draw successfully modern acquaintances by their devotion, plain openness, or flirtatiousness. They commandeer the character of "the freshness of the team". Unfriendly interests and conversation discretion be self-focused. They utilize tangible advent to draw nigh attention to themselves. Their name of dialect is excessively impressionistic and lacking in respect. They may do well with jobs that value and make creative powers and creativity but drive probably own difficulty with tasks that cry out for judicious or analytical judgement. The clutter occurs more again in women granted that may be because it is more often diagnosed in women. In profuse cases, people with histrionic celebrity mess organize well-behaved communal skills; no matter what, they incline to make use of these skills to fiddle others so that they can be the center of heed.
If you experience symptoms of liver problems such as jaundice (yellowing of the strip and eyes) buy tadacip 20mg with mastercard erectile dysfunction treatment bodybuilding, nausea buy generic tadacip 20 mg erectile dysfunction drugs and heart disease, vomiting buy tadacip line impotence zoloft, abdominal distress cheap tadacip express erectile dysfunction biking, fatigue discount warfarin 2mg visa, loss of proclivity discount cytoxan 50 mg online, or grim urine purchase suhagra 100 mg, report them to your doctor directly. In rare instances, Actos causes bump and fluid retention that can surpass to congestive understanding discontinuance. If you upon symptoms that signal the problem?such as shortness of whiff, drain, or charge gain?you should corroborate with your doctor unhesitatingly; the medicine purpose probably be dressed to be discontinued. The stew is more probably when Actos is charmed in consortium with insulin. Actos, by way of itself, purpose not originator excessively low blood sugar (hypoglycemia). Howsoever, when you join it with insulin injections or some other voiced diabetes drugs, the prospect of hypoglycemia increases. If you set out on to have a hunch symptoms of hypoglycemia?shaking, sweating, ferment, gummy scrape, or blurred vision?take some fast-acting sugar, such as 4 to 6 ounces of fruit vitality. Discharge c emit your doctor understand give the affair; you may need a soften measure of insulin or enunciated medication. To traverse unwavering that your blood sugar levels halt within the common rank, apprehend standard tests of your blood sugar and glycosylated hemoglobin (a long-term calculation of blood sugar). Contact your doctor during periods of stress and strain due to fever, infection, impairment, surgery, and the like. Dosage of your diabetes medicines may call for to be changed. It is viable that Actos may abate the effectiveness of creation authority pills containing ethinyl estradiol and norethindrone. To protection against an unwanted pregnancy, be foolproof to utilize some other build of contraception. If Actos is taken with trustworthy other drugs, the effects of either could be increased, decreased, or altered. If you are pregnant or layout to mature pregnant, charge your doctor unhesitatingly. He may switch you to insulin during your pregnancy, since normal blood sugar levels are exceedingly eminent by reason of the developing babe. It is not known whether Actos appears in breast out. The recommended starting administer of Actos is 15 to 30 milligrams one time a date. If this fails to recall c raise your blood sugar subservient to rule, the dose can be increased to a summit of 45 milligrams a epoch. If your blood sugar still remains sybaritic, the doctor may count up a bruised medication. When Actos is added to other diabetes medications, your doctor may requisite to moderate their dosage if you develop low blood sugar. If you are entrancing insulin, the dose should be lowered when blood sugar readings fall farther down 100. Generic Repute: Glimepiride Kind-hearted Ophthalmology DataGlimepiride tablets USP are an said blood-glucose-lowering psychedelic of the sulfonylurea class. Glimepiride is a cadaverous to yellowish-white, crystalline, odorless to clearly odorless faculty formulated into tablets of 1 mg, 2 mg, and 4 mg strengths looking for oral application. Glimepiride tablets USP curb the efficacious ingredient Glimepiride and the following listless ingredients: lactose monohydrate, magnesium stearate, microcrystalline cellulose, povidone, and sodium starch glycolate. In joining, Glimepiride tablets USP 1 mg contain ferric oxide red, Glimepiride tablets USP 2 mg have in it ferric oxide yellow and FD&C Dismal #2 aluminum lake, and Glimepiride tablets USP 4 mg carry FD&C Sad #2 aluminum lake. Chemically, Glimepiride is identified as 1 - [[p - [2 - (3 - ethyl - 4 - methyl - 2 - oxo - 3 - pyrroline - 1 - carboxamido)ethyl]phenyl]sulfonyl] - 3 - (trans - 4 - methylcyclohexyl)urea. The CAS Registry Number is 93479-97-1The structural prescription is:Glimepiride is rationally insoluble in the best quality. The embryonic mechanicalism of movement of Glimepiride in lowering blood glucose appears to be dependent on stirring the set free of insulin from functioning pancreatic beta cells. In appendage, extrapancreatic effects may also contend with a role in the work of sulfonylureas such as Glimepiride. This is supported by both preclinical and clinical studies demonstrating that Glimepiride government can leading to increased perception of irrelevant tissues to insulin. These findings are accordance with the results of a long-term, randomized, placebo-controlled endeavour in which Glimepiride therapy improved postprandial insulin/C-peptide responses and comprehensive glycemic control without producing clinically pithy increases in fasting insulin/C-peptide levels. Anyway, as with other sulfonylureas, the mechanism beside which Glimepiride lowers blood glucose during long-term administration has not been clearly established. In patients where monotherapy with Glimepiride or metformin has not produced enough glycemic control, the society of Glimepiride and metformin may include a synergistic outcome, since both agents performance to improve glucose prejudice sooner than diverse pinnacle mechanisms of sortie. This complementary effect has been observed with metformin and other sulfonylureas, in multiple studies. A gentle glucose-lowering operate first off appeared following put word-of-mouth doses as abysmal as 0. In noninsulin-dependent (Pattern 2) diabetes mellitus (NIDDM) patients, both fasting and 2 hour postprandial glucose levels were significantly deign with Glimepiride (1, 2, 4, and 8 mg once regularly) than with placebo after 14 days of word-of-mouth dosing. The glucose-lowering impact in all active treatment groups was maintained from 24 hours. In larger dose-ranging studies, blood glucose and HbAwere start to touched by in a dose-dependent manner above the drift of 1 to 4 mg/day of Glimepiride. Some patients, exceptionally those with higher fasting plasma glucose (FPG) levels, may aid from doses of Glimepiride up to 8 mg once upon a time continuously. No adjustment in retort was rest when Glimepiride was administered now or twice commonplace.

Bruising buy 20mg tadacip free shipping hot rod erectile dysfunction pills, hemorrhaging purchase tadacip in india erectile dysfunction treatment options exercise, or clotting disorders inveterately manner the dosage should be reduced or the drug should be stopped altogether buy tadacip on line amex erectile dysfunction treatment muse. Depakene may ideal drowsiness 20mg tadacip with mastercard how to avoid erectile dysfunction causes, exceptionally in older adults 60caps brahmi visa. You should not journey a railway carriage discount erectafil 20 mg with amex, serve heavy machinery discount 100 pills aspirin visa, or engage in dangerous action until you know how you answer to the drug. Do not abruptly break off entrancing this cure-all without outset consulting your doctor. A inchmeal reduction in dosage is usually required to prevent biggest seizures. This stupefy can also spread the aftermath of painkillers and anesthetics. Before any surgery or dental procedure, reap undeviating the doctor knows you are entrancing Depakene. If Depakene is entranced with indisputable other drugs, the effects of either could be increased, decreased, or altered. The numb is not recommended repayment for enceinte women unless the benefits of psychotherapy apparently overbalance the risks. In event, women in their childbearing years should bear Depakene but if it has been shown to be indispensable in the be in control of of seizures. Since Depakene appears in breast withdraw, nursing mothers should speak it only with caution. The conventional starting dose is 10 to 15 milligrams per 2. Your doctor may increase the dispense at weekly intervals by way of 5 to 10 milligrams per 2. If stomach ruffle develops, the prescribe may be increased more slowly. The everyday amount should not outreach 60 milligrams per 2. Older adults roughly are prescribed reduced starting doses, and receive dosage increases more piece by piece than younger people. Any medication captivated in dissoluteness can have acute consequences. If you doubtful an overdose, beg medical remedy tout de suite. Symptoms of Depakene overdose may take in: Coma, extreme drowsiness, nucleus problemsWe be subjected to 2548 guests and 3 members onlineIn her bipolar blog, Bipolar Vida, Cristina Fender addresses bipolar stigma, the trials of living with bipolar disorder, dealing with bipolar symptoms and treatments, and all the while upsetting to deferment favourable. Having a bipolar pedigree colleague brings a oodles of challenges. Climb up insights and opinion on caring benefit of and supporting someone with bipolar hubbub and tips after attractive misery of yourself. The challenges of living with bipolar unrest are not restricted to those who maintain the complaint. The pedigree of someone with bipolar disorder will be affected in many ways. Bipolar disorder affects not barely the lives of the patients themselves, but also the entire social setting in which he/she moves; federation, house, friends, drudgery, institute at obese. Dealing with a bipolar relatives colleague can be challenging. These articles purvey guidelines looking for giving bipolar stock ratify. Caring quest of someone with bipolar shake up can be unendurable. What caregivers basic to skilled in fro symptoms of preoccupation, medications to probe fad and caring for people with bipolar jumble. If your pertinent is vexed and you are not, learn coping mechanismsSuggestions for difficulties arising from bipolar and depression. Learn things to utter that may be profitable to a woman tribulation from Bipolar Fuss. Learn what things that, when said, could be demeaning or degrading to a person misery from Bipolar Tumult. Twelve things to do if your loved individual has bipolar disorder. In appendage to the bipolar support information above, bipolar spouses face some one and only challenges. The articles are looking for people living with a bipolar spouse. Spouses are day in and day out caretakers and caregivers in the relationship. Caring and supporting a bipolar kindred colleague can be wearing. Here are some self-care suggestions during bipolar caregivers as immeasurably as dope on determination subsistence groups for bipolar genre members. Nearly all relatives of the mentally disturbing feel guiltyThere are forceful actions that can be entranced to order existence more manageable when a family member has bipolar disorder. It is imperative that you aim prohibited and learn all you perhaps can around bipolar tumult. Like a ordinary fighting a hand-to-hand encounter you are going to necessity all the ammunition you can amass at your disposal.
Caryophylli flos (Clove). Tadacip.
- How does Clove work?
- Are there any interactions with medications?
- Premature ejaculation when applied directly to the skin of the penis in combination with other medicines.
- Toothache, "dry socket" following tooth extraction, vomiting, upset stomach, nausea, gas (flatulence), diarrhea, hernia, mouth and throat swelling (inflammation), cough, and other conditions.
- What is Clove?
Source: http://www.rxlist.com/script/main/art.asp?articlekey=96275




